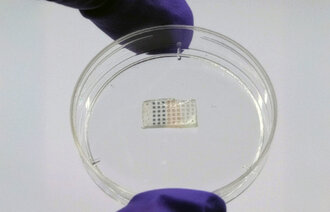
bilde av hjerteplasteret

Vil ha nasjonale retningslinjer for hjerteinfarkt-behandling

Helseminister Jan Christian Vestre (Ap) ber Helsedirektoratet om å lage forslag til nasjonale retningslinjer for hjerteinfarkt-behandling.
Det er om lag 10 000 tilfeller av akutt hjerteinfarkt i Norge i året, men så langt har vi ikke hatt nasjonale retningslinjer for behandling, skriver NRK.
– Det er viktig med slike retningslinjer fordi folk skal være trygge på at de får god helsehjelp når de trenger det. Samtidig er det viktig at vi har nasjonale, faglige retningslinjer som er tilpasset norske forhold. Det er det vi nå ber Helsedirektoratet om å utarbeide, sier helseminister Jan Christian Vestre.
– Et politisk ansvar
Vestre mener det er et politisk ansvar å sikre et godt behandlingstilbud i Norge.
– Men det er også et faglig spørsmål hvilken type behandling som skal gis, hvor den skal gis, og hvor raskt den skal gis. Det mener jeg vi trenger nasjonale retningslinjer for å vurdere.
Klinikkleder ved medisinsk klinikk på Universitetssykehuset Nord-Norge, Per Bjørnerud Rønning, ønsker nasjonale retningslinjer.
– Det er alltid bra å diskutere dette på tvers av fagmiljøene i hele landet, og sørge for at vi har lik innretning på tjenestene våre, sier han.

0 Kommentarer